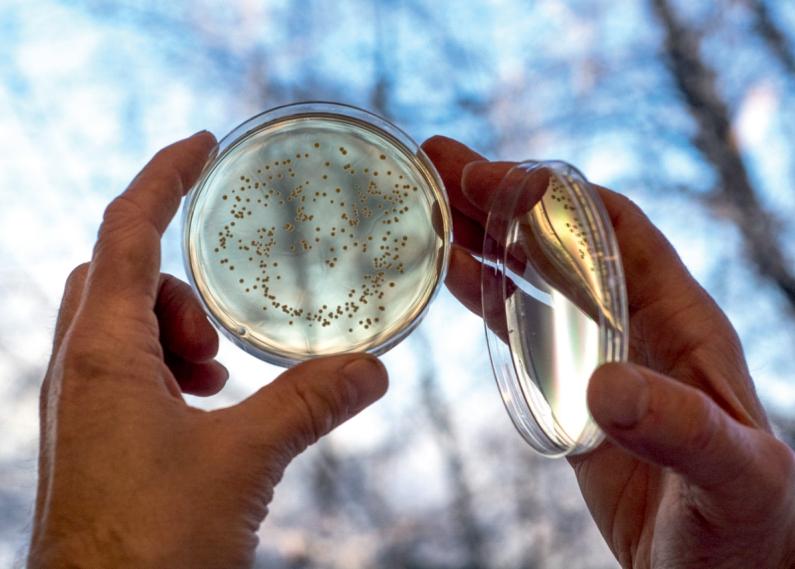

Elements of Progress
Understanding the Core Aspects of Innovations in the Life Science Niche Industry Insights
Gradual Rise of Women in the Stem Field




Understanding the Core Aspects of Innovations in the Life Science Niche Industry Insights
Gradual Rise of Women in the Stem Field




Womenaremakingsignificantcontributionsto
thefieldoflifesciences,drivinginnovations andadvancingknowledgeinnumerousareas. Thefieldoflifescienceisconstantlyevolving,andittakes strongleaderstodriveinnovationandbringbreakthroughs tothemarket.In2023,weareproudtorecognizethe10 mostinnovativewomenleadersinlifesciencewhoare changingthegameandpushingboundariesintheir respectivefields.
Womenarebeinginstrumentalinadvancingcancer research,developingnewtreatmentsandtherapies,and improvingpatientoutcomes.Thesewomenaredriving innovationinareassuchasbiotechnology,pharmaceuticals, genomics,andmore.
Womenscientistsareleadingthewayinthedevelopmentof personalizedmedicine,whichtailors’medicaltreatmentsto patientsbasedontheirgeneticmakeup,lifestyle,andother factors.Theyareleadingteamsandcompaniesthatare bringinglife-changingsolutionstopatientsaroundthe world.
Womenareplayingasignificantroleinthefieldof genomics,makingbreakthroughsinunderstandingthe humangenomeanddevelopingnewgenetherapies.They
arealsodrivinginnovationsinbiotechnology,developing newapproachestodrugdevelopment,tissueengineering, andregenerativemedicine.Womenscientistsaredriving innovationsinneuroscience,developingnewtechniquesfor brainimagingandexploringtheconnectionsbetweenthe brainandbehavior
Theircontributionstothefieldoflifesciencearepavingthe wayforahealthierandmoresustainablefuture.Weare honoredtorecognizetheseexceptionalwomenand celebratetheirachievementsinthelatesteditionofInsights Success,entitled“The10MostInnovativeWomen LeadersInLifeScience-2023.”
Theirstoriesserveasaninspirationtothenextgeneration ofwomenleadersinlifescience,remindingusaboutthe importanceofdiversity,inclusivityandequityindriving innovationandcreatingabetterfutureforall.
Flip through the pages and have a delightful reading experience.





Editor-in-Chief
Merry D'Souza
DeputyEditor Executive Editor Assistant Editors
Visualizer
David King
Senior Sales Manager
Marketing Manager
John Matthew
Technical Head
Technical Specialist
Ankita Pandharpure
Art & Design Director Associate Designer Sihanee M., Rouniyar A. Peter Collins
Business Development Manager
Sales Executives
David, Martin
Business Development Executives
Steve, Joe Jacob Smile Prachi M.
Digital Marketing Manager
Dominique T.
SME-SMO Executive Sagar L.
Circulation Manager
Research Analyst
Frank Adams
Database Management Technology Consultant

Robert Brown Stella Andrew David Stokes
sales@insightssuccess.com
April, 2023
FeaturedPerson
AllysonBower-Willner
Sr.DirectorofMarketing
Brief CompanyName
MölnlyckeHealthCare molnlycke.us
Innovara innovara.com
Merck merckgroup.com
Lykins
ColleenJ.Payne
Founder,CEO,Director ofOperations
DoloresJ.Schendel ChiefScientificOfficer
Dr.GiulianaVallanti
Sr.Directorof Marketing
EvelinaVågesjö CEOandCo-founder
JenniferS.Buell
PresidentandChief ExecutiveOfficer
PamelaContag CEO
KarunaTherapeutics karunatx.com
MCIDiagnosticCenter mcidiagnostics.com
MedigeneAG medigene.com
AGCBiologics agcbio.com
LytixBiopharma lytixbiopharma.com
MiNKTherapeutics minktherapeutics.com
BioEclipseTherapeutics bioeclipse.com
AllysonBower-Willnerinfluencesthelandscapebyleading teams,productlaunches,andmarketdevelopment.
BarriBlauveltisCEOofInnovara,aglobalpharmaceuticalbusiness andmanagementdevelopmentfirm.
UnderBelénleadership,Merckhasdefineditsstrategic ambitiontobecometheglobal21stcenturyscienceand technologypioneerandsetitsgoalof€25billioninGroup salesby2025.
WithCharmaine'sguidanceKarunaTherapeuticsisaclinicalstagebiopharmaceuticalcompanydriventocreateanddeliver transformativemedicinesforpeoplelivingwithpsychiatricand neurologicalconditions
ColleenisaserialEntrepreneur,NuclearMedicine Technologist,MotivationalSpeaker,andesteemedAuthor.She isthefounderandPresidentofMCIDiagnosticCenterandshe isblazingtrailsandmakinghistoryalongtheway
ProfSchendelwasDirectoroftheInstituteofMolecular ImmunologyoftheGermanResearchCenterfor EnvironmentalHealthattheHelmholtzCenterinMunich.
Dr.Giulianaisanexpertinthedevelopmentand industrializationofT-andhematopoieticcelltransduction processeswithlentiviralandretroviralvectors.
Evelinahasdevelopedmethodstosteerimmunecellfunctions anddelineatedanewmechanismofactionduringtissue regeneration.
JenniferS.Buell bringsmorethan25yearsof biopharmaceuticalexperience,leadingteamstoadvance discoverycandidatesthroughtoclinicaldevelopmentto commercialization.
Pamelaisdedicatedtosolvingunmethealthcareand environmentalneedsthroughthediscoveryandfosteringof scienceandtechnology
BarriBlauvelt CEO BelénGarijo ChairoftheExecutive BoardandCEO Charmaine ChiefCommercial Officer(CCO)











Implementinghervastmarketingexperiencein
healthcare,understandingthebreadthanddepth, includingmedicaldevices,pharmaceuticals,biologics, precisionmedicine,andinvitrodiagnostics,Allyson Bower-Willnerinfluencesthelandscapewithleading teams,productlaunches,andmarketdevelopment.

AstheSr.DirectorofMarketingatMölnlyckeHealth Care,shehelpstopromotetheorganizationalgoalsof providinghigh-performingsolutionsthatdelivermorevalue tocustomers.
WecaughtupwithAllysontolearnmoreabouthowher professionaljourneyhasshapedhercurrentposition,having facedseveralchallengesandleadinghertroughthem.
Below are the highlights of the interview:
Brieflydescribeyourprofessionaljourneyupuntilnow.
IwouldsaythethemeformycareerwithinMedical Deviceshasbeen“breadth.”
Myconcentrationingraduateschool,Operations Management,certainlydidnotdefinemycareer.Itesteda fewdifferentfunctions–Operations,R&D, Regulatory/Clinical,QA,Reimbursement,Business Development,andevenSalesbeforelandinginMarketing–byfarmyfavorite.I’vealsoworkedinvariousmedical devicespecialties–GI,Cardiovascular,Interventional Radiology,VascularSurgery,GeneralSurgery,Urology& Gynecology,andWoundCare.I’veworkedindependently asaheadofmyowncompany,atFortune100companies, andeverythinginbetween.Ifindthatpullingthebestfrom eachofthemhasmademestrongerasamarketerand, particularly,amuchbetterstrategist.Ithinkmyexposureto multiplefunctions,variousspecialties&inmanydifferent sizedcompaniesgivesmeabroaderperspective,makingit easierformetosolvemarketingproblems.
Whatalsocannotbeunderstatedismynetwork,which includespeoplefromsomanyfunctions,specialtiesand
typesofcompanies.Iamgratefulforthisnetworkevery singleday
Alongtheway,I’vemetsomeincrediblyenlightenedand sensitivemen,andI’vecomeacrossafewwhosawmeas anoutsider–andthosewerethehardesttimesforme.The inequalitythatremainsinpocketsinourindustryis puzzlingtome,andIseethe(oftensubtle)injustices happeninbusinessoften.Inthisindustry,I’vealways workedamongmen.Myundergraduateschoolhadaratio of1womanforevery7men.WhileIwasworkingin consultingintheMedicalDeviceindustry,Ihadmyfirst babyshowerandworkandtheattendeesincludedonlyme and17men.Andso,whileI’vebeenabletoworkthrough genderissueswithsomesuccess,Idoseethemcontinuing andI’vededicatedalotoftimetothemovertheyears.
Iparticipatedin“LeanIn”networks,joinedmycompany’s businessresourcegroupsforwomen,leveragedmentors, andmentoredyoungerwomen.I’vetookonaleadership positiontolaunch&co-leadmycompany'sProfessional Women’sAlliance.IalsoleadtheSoutheasternLife Sciences&SoutheasternLifeScienceWomen@SLSgroup tosupportwomeninthefield.Ialsoraised3childrenalong theway,andsoIfullyunderstandthechallengeswomen faceontheparentingfront.
Women’sissuesremaininourindustry,andI’mstill committedtodomyparttoensuregenderdoesn’tcome intoplaywithregardtoprofessionalopportunity&reward.
Whatsignificantimpacthaveyoubroughttothelife scienceindustry?
MyworkwiththeSoutheasternLifeSciences& SoutheasternLifeSciencewomen’sgroup(Medtech Women@SEMDA&Women@SLS)hashadthemost impactonthebroaderLifeSciencecommunityandis amongthemostrewardinginmycareer.Ourmissionwas toenhanceopportunitiesforwomenintheMedTechand
“
My work with the Southeastern Life Sciences & Southeastern Life Science group has had the most impact on a broad community, and is among the most rewarding in my career.

Allyson Bower-Willner, Sr. Director of Marketing Mölnlycke Health Care
lifescienceindustries.We’veheldmanyforums,including webinarsandconferences,tohelpexpandthenetworksand providenewskillstowomenintheindustry Asmembersof SEMDA/SLS,we’vekeptwomen’stopicsfrontandcenter, oftensponsoringkeynetworkingeventsandkeynote sessionsenjoyedbyallmembers,womenandmenalike.
TellusaboutMölnlyckeHealthCareanditsfoundation pillar.
ThecompanyIworkwithnow,MölnlyckeHealthCare, promotesspecifichigh-performancebehaviorsthatare promotedandreinforcedeveryday–includingthingslike entrepreneurship,teamperformance,taking ownership/responsibility&customer-centricity These corporatevaluescomplementmyownandallowmeto authenticallyworktowardcreative,innovativesolutions withoutfearoffailure.Atthesametime,ourProfessional Women’sAllianceallowsmeanoutlettosimultaneously ensurewomen’svoicesareuplifted&nurturedaspartof ourorganization’sfabric.
HowdoesMölnlyckeHealthCarepromoteworkforce flexibility,andwhatisyourroleinit?
AspartofourProfessionalWomen’sAlliance,we’ve supportedprogramsthathelpreinforceworkplace flexibility.Mölnlyckechallengesthestatusquo-our companyhasmovedfromafull-timeoffice-basedmodelto a2-dayperweekmodel,withflexibleworkschedulesbeing supportedbothinfrastructurally&culturally.Theflexibility helpsallofusbalanceourlivesandminimizeinefficiencies duetounnecessarytravel.Ithelpsusretainpeople.When peoplefacechallengingtimes,givingthemtheflexibility theyneedincreasestheirloyaltytoourcompany
Whatisyourtakeontechnology’simportance,andhow areyouleveragingit?
Thereisnoturningback–technologyisadvancingrapidly, challenginganycompanytokeepup.We’reconstantly assessingnewtechnologiestohelpussupportourcorporate culture&workflexiblybutalsotoaugmentourclinical offering.Fromremoteworkingtosocialnetworking&AI, itisinfiltratingeveryaspectofourwork.Myphilosophyis thatifwegetleftbehindontechnology,wewillbeleft behindintheindustry.
Whatwillbethenextsignificantchangeinthelife scienceindustry,andhowareyoupreparingforit?
Thismayseemwayoutthere,butchangesarecomingfor front-lineproblem-solvingviaAI&machineautomation. Asanindustry,wemustembracethesimplestoftheseas quicklyaspossibletoprepareourselvesforthosebroader changes.Wemustembracetechnologytominimizespeedto-executionatafractionofthecost.
AnexampleistheuseofAItoolssuchasOpenAI.In marketingforexample,“copy”(originaldocumentation) developmentisoftenagatingitem&assignedtolowerlevelmarketers.ButAIcancreatethatfirstdraftina fractionofthetimeahumancanaccomplishthesametask. AIcanhelpusdevelop&finalizemarketingcopyand materialsfasterandlessexpensively.Frommyperspective, itwillbenotimeatallbeforeAIisdoingsimilarworkin almosteveryotherfunctioninourindustry.Ireallydon’t thinkwecanevenimaginehowmuchofanimpact technologieslikeAI&machinelearningwillhaveonour lives,evenjust2-3yearsfromnow
Whatareyourgoalsintheupcomingfuture?
Mynextprofessionalgoalistoleadmydepartmentin minimizationofbothtimesandcosttoexecuteeven stronger,broader,andmorecompellingpositioning, messaging,andpromotion.Achievingthisgoalwillhelpus providemorecost-effectiveaccesstolife-changingmedical devicesforourcustomers.Thisisparticularlyimportant hereintheUStocontinuetoleadtheworldinhealthcare. Thecost-effectivenessofourmedicalsolutionshastotakea morefront-and-centerpositionacrosstheboardfor suppliersandprovidersalike.
Whatadvicewouldyouliketogivethenextgeneration ofaspiringbusinessleaders?
Aformerbossofminesaidthekeytoasuccessfulstart-up istosolveabigproblem,andthat’salwaysstuckwithme. I’dloveournewergenerationtobringyourtechnical expertiseandhelpussolvesomebigproblemslike reducingcostwhileimprovingcare!Idon’thavethe technicalskillsyou’vegrownupwith,andyoucanuse thoseskillstohelpusspringboardtheindustrytoanew efficiencystandard.Therearemillionsofpeoplerighthere intheUSwithproblemsyoucansolve,andifyousolveit foroneperson,chancesaregoodthatthereareotherswho canusethatsolutiontoo!







Overtheyears,wehaveseenagradualriseof
womenintheSTEMfield.Whilethereisstilla longwaytogo,progressisundeniable.Hereare someofthefactorsthathavecontributedtotheincreasing participationofwomeninSTEM:

Education:Therehasbeenasignificantincreaseinthe numberofwomenpursuinghighereducationinSTEM fields.Manyuniversitieshavemadeanefforttorecruitand retainfemalestudentsinSTEMprograms.
Rolemodels:ThevisibilityofsuccessfulwomeninSTEM fieldshasencouragedyounggirlstoconsidercareersin theseareas.WomeninSTEMhavebecomemorevisiblein
themediaandinpopularculture,makingiteasierforyoung girlstoimaginethemselvespursuingthesecareers. Mentoring:Theimportanceofmentorshipcannotbe overstated.ManysuccessfulwomeninSTEMfieldshave takenituponthemselvestomentoryoungerwomenand providethemwithguidanceandsupport.
Advocacy:Organizationsandgroupshaveformedto advocateforwomeninSTEM.Thesegroupsworkto increaseawarenessandunderstandingofthechallenges womenfaceinthesefieldsandprovideresourcesand supporttoovercomethesechallenges.
Corporateinitiatives:Manycorporationshaverecognized thebenefitsofhavingadiverseworkforceandhavetaken stepstoincreasethenumberofwomeninSTEMfields. Thisincludescreatingprogramstorecruitandretain women,offeringmentorshipandnetworkingopportunities, andprovidingprofessionaldevelopmentopportunities.
ProponentsofclosingthisgendergapintheSTEMfield pointsoutthatthisgapnotonlyreflectsunfairconditions andpoortreatmentofwomeninthisfield.Furthermore,it alsoreducesthequalityofworkandinnovationsbeing extractedfromthesefields.
Itisasubjectofrecommendationandfactsthatindicate scientificprogressreliesonuniquesolutionsthatare emergingfromdifferentperspectives.Closingthegender gapmakeSTEMfieldsmorediverse,also,redefinesthe assuranceofproblem-solvingapproacheswithavarietyof differentperspectives.
Althoughthebroadgendergapthatexistsacrossthe STEMfieldsbecomesatopicofdiscussion,thereisa greatdealofvarietyamongdifferentSTEMsubfields whenitcomestotheexactscaleandnatureofthisgap.
Somesubfieldshavenogapatallandfavourwomen ingraduation,andjobplacement.Insubjectslike socialscience,thereisagreaternumberofwomen ifcomparedtomen,anditremainsstrongly favourabletowardswomen.

Itisafactofassurancethatwomenwould benefitfromthecreationofmore inclusiveatmospheresinSTEMfields, thesefieldsasawholecanbecome moreengaging.
Afieldlikescienceworksand functionsatitsbestwhenitconsiders
awiderangeofdiverseperspectives.Byexcludingwomen, suchfieldsnotonlyexcludeawiderangeofextremely talentedfutureleadersbutalsofreshperspectivesthatcould beusedtocreateinnovativeapproachestoresolve problems.
Engagingwomeninstemfieldshasimprovedthequalityof workbeingexecutedinthosefieldsandithasopenedup distinguishedcareeropportunitiesforwomen.
Ingeneral,researchhasdisplayedthat,‘diverseworkplaces arehappierinnatureandmoreproductive,’indicatingthat STEMorganizationscoulddobetterforthemselvesby beingmoreinclusive.

Theideaofthegenderequalityparadoxisnotwithoutits problems.Criticspointoutthatcountrieswithpoor representationinSTEMfieldshavealonghistoryof excludingwomenfromscienceandmathematics,whichhas beendeeplyembeddedintotheculturethatsurrounds younggirlsastheyaregrowingup.
Theyalsopointoutthatthereisnogapinabilitysince researchersfoundthatgirlsperformedaswellorbetterthan boysonSTEMtestsinmostcountries.
TruesolutionstothegendergapinSTEMfieldsworkon multiplelevels.Exclusionbeginsinchildhood,whenyoung girlshavebeenpushedawayfromcreativefieldslike science,andmathematics,andareencouragedtoadopt morecare-orientedwork.
Thisscenarioisdrasticallychangingasparentsare encouragingandremindingtheirchildrenthattheycan growuptodoanythingthattheywant.Parentsarealso providingawiderangeofopportunitiesforchildrento exploretheirinterests,includingthoserelatedtoSTEM, suchascodingcampsandsciencefairs.
Ineducation,scholarshipsandgrantsarestrivinghardto bringwomenintoSTEMdepartments.However,these departmentsmustdoeverythingintheirpowertoprevent discriminationandsexismagainstfemalestudentsto improvepreservationrates.
Intheworkplace,employeesmustidentifyandaddressthe discriminationintheirhiringpracticessotheycangenerate adiverseworkplacethatenhancesproductivityamongtheir employees.
Outsideofschoolandtheworkplace,broadersocietal changesarealsocalledfor Womenareoftenharderhitbya couple’sdecisiontoraiseafamily,forcingthemtotake
moretimeoffofworkduringcriticalperiodsintheir careers,suchasearlyonatanewjoborevenduringtheir doctoralstudies.
Despitethesesituations,womenaremakingnoteworthy progressnotonlyinSTEMfields,butalsointheir profession,andarebreakingthestereotypes.
ProponentsofclosingthisgendergapintheSTEMfield pointsoutthatthisgapnotonlyreflectsunfairconditions andpoortreatmentofwomeninthisfield.Furthermore,it alsoreducesthequalityofworkandinnovationsbeing extractedfromthesefields.
Itisasubjectofrecommendationandfactsthatindicate scientificprogressreliesonuniquesolutionsthatare emergingfromdifferentperspectives.Closingthegender gapmakeSTEMfieldsmorediverse,also,redefinesthe assuranceofproblem-solvingapproacheswithavarietyof differentperspectives.
AlthoughthebroadgendergapthatexistsacrosstheSTEM fieldsbecomesatopicofdiscussion,thereisagreatdealof varietyamongdifferentSTEMsubfieldswhenitcomesto theexactscaleandnatureofthisgap.
Somesubfieldshavenogapatallandfavourwomenin graduation,andjobplacement.Insubjectslikesocial science,thereisagreaternumberofwomenifcomparedto men,anditremainsstronglyfavourabletowardswomen.
Itisafactofassurancethatwomenwouldbenefitfromthe creationofmoreinclusiveatmospheresinSTEMfields, thesefieldsasawholecanbecomemoreengaging.
Afieldlikescienceworksandfunctionsatitsbestwhenit considersawiderangeofdiverseperspectives.By excludingwomen,suchfieldsnotonlyexcludeawide rangeofextremelytalentedfutureleadersbutalsofresh perspectivesthatcouldbeusedtocreateinnovative approachestoresolveproblems.
Engagingwomeninstemfieldshasimprovedthequalityof workbeingexecutedinthosefieldsandithasopenedup distinguishedcareeropportunitiesforwomen.
Ingeneral,researchhasdisplayedthat,‘diverseworkplaces arehappierinnatureandmoreproductive,’indicatingthat STEMorganizationscoulddobetterforthemselvesby beingmoreinclusive.
Theideaofthegenderequalityparadoxisnotwithoutits problems.Criticspointoutthatcountrieswithpoor representationinSTEMfieldshavealonghistoryof excludingwomenfromscienceandmathematics,whichhas beendeeplyembeddedintotheculturethatsurrounds younggirlsastheyaregrowingup.
Theyalsopointoutthatthereisnogapinabilitysince researchersfoundthatgirlsperformedaswellorbetterthan boysonSTEMtestsinmostcountries.Truesolutionstothe gendergapinSTEMfieldsworkonmultiplelevels. Exclusionbeginsinchildhood,whenyounggirlshavebeen pushedawayfromcreativefieldslikescience,and mathematics,andareencouragedtoadoptmorecareorientedwork.
Thisscenarioisdrasticallychangingasparentsare encouragingandremindingtheirchildrenthattheycan growuptodoanythingthattheywant.Parentsarealso providingawiderangeofopportunitiesforchildrento exploretheirinterests,includingthoserelatedtoSTEM, suchascodingcampsandsciencefairs.Ineducation, scholarshipsandgrantsarestrivinghardtobringwomen intoSTEMdepartments.However,thesedepartmentsmust doeverythingintheirpowertopreventdiscriminationand sexismagainstfemalestudentstoimprovepreservation rates.
Intheworkplace,employeesmustidentifyandaddress discriminationintheirhiringpracticessotheycangenerate adiverseworkplacethatenhancesproductivityamongtheir employees.

Outsideofschoolandtheworkplace,broadersocietal changesarealsocalledfor Womenareoftenharderhitbya couple’sdecisiontoraiseafamily,forcingthemtotake moretimeoffofworkduringcriticalperiodsintheir careers,suchasearlyonatanewjoborevenduringtheir doctoralstudies.Despitethesesituations,womenare makingnoteworthyprogressnotonlyinSTEMfields,but alsointheirprofession,andarebreakingthestereotypes.
Whileprogresshasbeenmade,thereisstillalotofworkto bedone.WomeninSTEMcontinuetofacechallenges, includingbiasanddiscrimination,lackofaccesstofunding andresources,andwork-lifebalanceissues.However,the increasingvisibilityofwomeninSTEM,combinedwiththe effortsofadvocates,mentors,andorganizations,offershope thatwewillcontinuetoseeariseinthenumberofwomen pursuingandsucceedinginSTEMcareers.

Makingtheuncurablecurableistheaimofthe cellandgenetherapysub-fieldofthe pharmaceuticalindustry.Itisthenextfrontierof healthcarethatwillrevolutionizetreatments,potentially cureincurablediseases,andtransformpatientlives completely.
Oneofthetrailblazersofthisstill-developingdisciplineis Dr.GiulianaVallanti,HeadofDevelopmentandGlobal HeadofR&DforCellandGeneTherapyatAGC Biologics.
Dr.Giulianaisanexpertinthedevelopmentand industrializationofT-andhematopoieticcelltransduction processeswithlentiviralandretroviralvectors.Shehas workedonthedevelopmentofGMPprocessesforlargescalevectorproductionandpurificationforlentivirus, retrovirusandAAV.Sheisdesigningprocessesthathelp scaleandcommercializecellandgenetherapies,making themavailabletothegeneralpopulation.
AGCBiologicsoffersdeepindustryexpertiseand customizableservicesandstrivestoprovideinnovative solutionstoitscustomers,helpingthemreachtheirgoals andacceleratetheirprojectsatourcGMP-compliant facilitiesintheUS,Europe,andJapan.Italsohelps facilitateapprovalandmanagespendingduringtheproduct lifecycle.
Inanexclusiveinterviewwith Insights Success,Dr. GiulianaVallantisharesdevelopmentsinthefieldofCell andGeneTherapyandherchallengesinpioneeringlifechangingwork.
Below are the highlights of the interview: Brieflydescribeyourprofessionaljourneyupuntilnow.
MycurrentroleistheHeadofDevelopmentandGlobal HeadofCellandGeneTherapyR&DatAGCBiologics,a leadingglobalContractDevelopmentandManufacturing
Organization(CDMO).IamabiologistwithaPh.D.inCell andGeneandhaveworkedinthisamazingfieldsincethe beginningofmycareer
Mymainresponsibilityistodevelopprocessesand analyticaltestingforviralvectorproductionandgenetically modifiedcells.Myteamdevelopsmanufacturingprocesses forourcustomers,aswellasnewplatformsand technologiesaimedatimprovingcellandgenetherapy productioninthefuture.
Whatchallengesdidyoufacealongtheway?
Themainchallengeisthatthefieldisstillveryyoungand immature,sostandardsandbestpracticesarefinite. However,thisisalsothemostinterestingpartofmyjob. Weareconstantlysearchingfornewsolutionsand techniquestoensureweproduceahigh-quality,safe,and functionalproduct.Thebeautyofcellandgenetherapiesis theircurativenaturetoverydevastatingdiseases.Butsince thetherapyismadeupofthepatient’sowncells,findinga waytogenetically“fix”themremainsasignificant challenge,andmyjobentailsjustthat–achievingawayto doit.
ThecoreteamatourAGCBiologicsMilansitehasbeen workingthroughthesechallengesformorethan20years, sowhilethisindustryisyoung,myteammateshaveabroad depthofexpertiseinthisspace.Thesitewasthefirst approvedinEuropeforGMPmanufacturingofcelland geneproducts,andwehavedevelopedthreecommercial productsforpatientsinneed.
Whatsignificantimpacthaveyoubroughttothelife scienceindustry?
Cellandgeneisoftenconsideredasthenewfrontierof personalizedmedicine,andIamveryproudtobepartof thisfield.MyteamandIworkhardeverydaytoensure thesetreatmentstranslatefromtheresearcher’sbenchtothe patient’sbedside.Thankstowhatwedo,incollaboration

withourcustomersandpartners,wehavesavedmorethan 150infantsaffectedbydevastatinglethalrarediseaseswho arenowlivinganormallife(ex:immunodeficiencies, lysosomalstoragediseases,hemoglobindisorders).As pioneersinthisfield,theteamatourAGCBiologicsMilan sitehelpedbringtomarketthefirsttwoex-vivogene therapiesapprovedworldwide.
TellusaboutAGCBiologicsanditsfoundationpillar.
AGCBiologicsisaglobalCDMOproviding pharmaceuticaldevelopmentandmanufacturingservices forprotein-basedbiologicsandcellandgenetherapies.We specializeinthefollowingmodalitiesandsubstances, mammalianandmicrobial-basedtherapeuticproteins, recombinantDNA,plasmidDNA(pDNA),Messenger RNA(mRNA),viralvectors,andgeneticallyengineered cells.
My team and I work hard every day to ensure CGT treatments translate from the researcher’s bench to the patient’s bedside. Thanks to what we do, we have saved more than 150 infants affected by devastating lethal rare diseases who are now living a normal life.
Ourmissionistoworksidebysidewithourcustomersin ordertoimprovepatient’slivesbybringingnew biopharmaceuticalstomarket.AGCbiologicsvaluesare Innovation&OperationalExcellence,Diversity, Environment,andIntegrity
HowdoesAGCBiologicspromoteworkforceflexibility, andwhatisyourroleinit?
Ourteamsarecommittedtohighqualityandexecution standards.Everypersonknowsthatbymeetingour customers’needs,wemeettheneedsofpatients,improving –andoftensaving–lives.Ourcustomersentrustuswith thisenormousresponsibility,andwecouldnotmakeit happenwithoutourpeople.Byputtingourpeoplefirst,we helpourteamsdeliverforourcustomersandtheirpatients.

AGCBiologicspromotesahealthywork-lifebalance becausewebelievethatbysupportingouremployees’wellbeing,theycometoworkfocused,efficient,andproductive. Withmostofouractivitiescarriedoutinlabswithvery sophisticatedequipment,weareoftenrequiredtoworkonsite.Still,wehaveastructurethatallowsforsomeremote andhybridworkingacrosstheentireorganization.
Whatisyourtakeontechnology’simportance,andhow areyouleveragingit?
Technologiesevolveveryrapidlyand,particularlyinthe CellandGenefield,weneednotonlytoremainuptodate onnewones,butwealsostrivetodesignanddefinenew flows“outoftheblue”byadaptingtechnologiesdesigned forotherscopesandapplications.However,whenpossible, wedotrytoleveragepracticalsolutionsandpracticesfrom otherfieldsratherthanreinventingthewheeleverytime.
Whatwillbethenextsignificantchangeinthelife scienceindustry,andhowareyoupreparingforit?
Undoubtedly,afterclassicalchemistryfollowedby biotechnology,cellandgenetherapyisthefutureof medicine.Thefieldisstillinitsembryonicphase,and everythingwedoremainsverymanual.Thechallengeisto movethisfieldintoarealindustrywithlarge-scale, automated,andreliablesystemsandtechnologythatwill makethesetherapiesmoreaffordable,robust,andsafe.To
continueleadingtheway,aswehavedoneforthelast25 years,weareinvestingsignificantlyintechnicalinnovation, capacity,andscalability. Whatareyourgoalsintheupcomingfuture?
MygoalistodoasmuchasIcantoworktowardsmaking CellandGeneTherapymoreaccessibletoawider population.Bydevelopingnewerandbetterprocesses, thesetherapiesaremanufacturedsafely,timely,and affordably,thusensuringtheirsustainability.Personally,I’m veryhappytocontinuemyroleasamentortoyoung scientistswhoworkwithmebytransferringmypassionfor thesubjectandtechnicalskillsthatareafundamental requirementinthisfield.
Whatadvicewouldyouliketogivethenextgeneration ofaspiringbusinessleaders?
Mymainsuggestionistofollowyourpassionsandinvest timeandenergyineducationandlearningatthebeginning ofyourcareer.Beopen-minded.Youcanlearnfrommany ofthosearoundyou,notonlyfromyourmanager.Moveout ofyourcomfortzoneasmuchaspossible,eventhoughit maybechallengingatfirst–thisistheonlywaytogrow Chooseajobthatbringsasmiletoyourfacewhenyou wakeupinthemorning.Thismakesahugedifference!









Thelifesciencesectorhasexperiencedmany
advancementsinrecentyears,whichhaveledtothe developmentofnewtreatmentsandtherapiesfora varietyofdiseases.Innovationinthelifescienceindustry referstothedevelopmentofnewproducts,technologies, andprocessesthatimprovehealthcareoutcomesand enhancethequalityoflife.Thefollowingaresomeofthe coreaspectsofinnovationinthelifescienceniche:
ComprehensiveResearchandDevelopment:Research anddevelopmentarecrucialtothelifescienceindustry. CompaniesinvestsignificantresourcesinR&Dtodevelop newdrugs,therapies,andmedicaldevicesthatcanimprove healthoutcomesforpatients.R&Dinvolvestheuseof advancedtechnologiesandscientificmethodologiesto identifynewtreatmentsandcuresfordiseases.
Collaboration:Collaborationbetweenacademia,industry, andgovernmentisessentialforinnovationinthelife scienceniche.Collaborativeeffortscanhelptofacilitatethe exchangeofknowledgeandexpertise,leadingtothe developmentofnewproductsandtherapies.
RegulatoryEnvironment:Theregulatoryenvironment playsacriticalroleinthelifescienceindustry.Regulations areinplacetoensurethatnewproductsandtherapiesare safeandeffectiveforpatients.Theregulatoryprocesscan becomplex,andcompaniesmustnavigatetheregulatory landscapecarefullytobringnewproductstomarket.
Investment:Investmentisnecessaryforinnovationinthe lifescienceniche.Companiesneedfundingtosupport R&Defforts,clinicaltrials,andthecommercializationof newproducts.Investorsalsoplayacrucialroleinproviding


thecapitalnecessarytobringnewtherapiesandproductsto market.
DigitalTechnologies:Digitaltechnologiessuchasartificial intelligence,machinelearning,andbigdataanalyticsare transformingthelifescienceindustry Thesetechnologies arehelpingcompaniestoidentifynewdrugtargets, optimizeclinicaltrials,andpersonalizetreatmentoptions forpatients.

Artificialintelligenceisplayinganincreasinglyimportant roleinthelifescienceindustry AItechnologiescananalyze vastamountsofdatatoidentifynewdrugtargets,optimize clinicaltrials,andpersonalizetreatmentoptionsfor patients.
TheuseofArtificialIntelligenceandMachineLearningin thelifescienceshasimproveddrugdiscoveryand developmentbyanalyzinglargedatasetsandidentifying potentialdrugcandidates.
PersonalizedMedicine:Personalizedmedicineisan emergingtrendinthelifesciencenichethatfocuseson developingtreatmentsthataretailoredtoindividual patients'geneticandmolecularprofiles.Personalized medicinecanimprovetreatmentoutcomesbyidentifying patientswhoaremorelikelytorespondtospecific therapies.Precisionmedicineisanapproachtopatientcare thatconsidersanindividual'sgeneticmakeup,lifestyle,and environmentwhendeterminingthemosteffective treatment.Thisapproachhasledtothedevelopmentof targetedtherapiesforcancerandotherdiseases.
GeneTherapy:Genetherapyisapromisingareaof medicalresearchthataimstotreatorcuregeneticdisorders byintroducingnew,healthygenesintothepatient'scells. Therehavebeenseveralrecentinnovationsingenetherapy thathaveadvancedthefieldandholdgreatpromiseforthe future.
Genetherapyinvolvestheintroductionofgeneticmaterial intoapatient'scellstotreatorpreventdisease.Gene therapyhasthepotentialtoprovidelong-lastingoreven permanentcuresforgeneticdiseases.CellandGene Editing:Cellandgeneeditingtechnologies,suchas CRISPR-Cas9,arerevolutionizingthelifescienceindustry byenablingprecisemodificationstoDNAsequences.Cell andgeneeditingtechnologieshavethepotentialtotreata widerangeofdiseasesanddisorders,includingcancer, geneticdiseases,andviralinfections.
GeneeditingtechnologiessuchasCRISPR-Cas9have revolutionizedthewayscientistscanstudyandmanipulate genes.Thesetechnologieshavethepotentialtocuregenetic diseases,preventinheriteddisorders,andevencreatenew treatmentsforcancerandotherdiseases.
DigitalHealth:Digitalhealthtechnologies,suchas wearabledevices,mobilehealthapps,andtelemedicine,are transformingthewayhealthcareisdeliveredandmanaged. Digitalhealthtechnologiescanimprovepatientoutcomes, reducecosts,andincreaseaccesstocare.

CollaborativeResearch:Collaborativeresearchis becomingmoreprevalentinthelifescienceindustryas companiesseektoshareknowledgeandexpertiseto acceleratethedevelopmentofnewtherapiesandproducts.
Insummary,innovationinthelifesciencenicheisdriven byresearchanddevelopment,collaboration,theregulatory environment,investment,anddigitaltechnologies. Companiesthatcaneffectivelyleveragethesecoreaspects ofinnovationarewell-positionedtodevelopnewproducts andtherapiesthatcanimprovehealthcareoutcomesand enhancethequalityoflifeforpatients.


Womenhavebeensignificantlycontributingto medicinethroughouthistory,andwehave benefitedfrommanyamazingdiscoveriesmade byfemalescientists.FamousexamplesincludeRosalind Franklin'scrucialworkonunderstandingthemolecular structuresofDNAandMarieCurie'sdiscoveryofradium, whichcontributedtothedevelopmentofthex-ray.What aboutthewomenwhoarecurrentlyreshapingthelife sciencesindustry,though?
EvelinaVågesjöistheCo-founderofIlyaPharmawitha Ph.D.inphysiology,anMBAwithafocusonfinance,anda MnA.Shedevelopedmethodstosteerimmunecell functionsanddelineatedanewmechanismofactionduring tissueregenerationandhasoverseentheprojectfromits conceptionthroughclinicalproofofconceptandcompany growthEvelinaisalsoaboardmemberofLytix Biopharma(LYTIX).
Fascinatedbytheworkingsofthehumanbody,Evelina, bornandraisedinSmåland,Sweden,beganresearchinga waytosteerimmunecellbehaviourlocallyasaprojectfor herdoctoralthesisstudiesatUppsalaUniversity.
Evelinaalsoholdstwobusinessdegrees,andI'minterested inlifesciencestrategyandfinancewithagoalofenhancing health. "I got the chance to study immunophysiology, and I was able to study in real-time how bodily functions work," she says. "I was able to observe how immune cells regulate blood flow in injured tissue."
Havingmanagedherprojectfromaninitialideatoclinical proofofconceptandthescalingofthecompany,today,at age35,Evelinahasbeenrecognisednumeroustimesforher achievements.Forexample,shehasbeenselectedforthe SpringboardEnterprises’HealthInnovationHubinthelife sciences,andshewasoneoftherecipientsoftheMIT InnovationsUnder35awardin2019.
Below are highlights of the interview that shed light on Evelina Vågesjö’s journey, which began as a project for her doctoral thesis and grew into a clinical-stage biopharmaceutical company:
Brieflydescribeyourprofessionaljourneyupuntilnow.
About10yearsago,Iwasveryinterestedinsinglemutation diseasesoftheskin,whichwereoptimalforthe developmentofthefirstgenetherapies.Thefieldwasinits earlystagesbackthen.Alwaysfascinatedbythehuman bodyandcuriousaboutwhattheimmunesystemand immunecellsdoduringhomeostasis,injury,anddiseasein thecirculationandinthetissue.Iseemtobecollecting degrees,notintentionallythough,withaMastersin Biomedicine,aPhDinPhysiology,andaBScin ManagementAccounting,allthreefromUppsala University,andanMBAinFinanceandM&Afrom EdinburghBusinessSchoolatHeriot-WattUniversity
In2016,Ico-foundedIlyaPharmaABbasedonmy researchandassociatedintellectualproperty Thecompany nowdevelopslocal-actingimmunotherapiesfromitsown platforminsyntheticbiology.The3clinicalprogrammes todayengage40peoplefrom6countriesand>30 subcontractors.Idevelopedtheinitialproofofconceptand havemanagedtheprojectsinceitstarted;nowIleadthe scalingupphaseasrequiredwiththeclinicaldevelopments, especiallyfinancing,intellectualpropertydevelopmentand management,businessdevelopments,andcommunications withindustrystakeholdersandbigpharma.Haveraised>25 MUSDtotheprojectssofarandledthestrategic acquisitionofoneofourvendors,NordicBioanalysisAB, in2021.
Since2021,IhaveservedontheBoardofDirectorsfor LytixBiopharma,afantasticclinical-stageimmunooncologycompanysolvingtheproblemoftreating
 Evelina Vågesjö Co-founder Ilya Pharma
Evelina Vågesjö Co-founder Ilya Pharma
Evelina has developed methods to steer immune cell func�ons and delineated a new mechanism of ac�on during �ssue regenera�on.
heterogeneoustumours,withbothpartnered-andfully ownedassetsinphase2developmentsinmultiplecancer indications.
Whatchallengesdidyoufacealongtheway?
Mixedmessagesandslowprocesses!Havelearnedto navigatecomplexandversatileenvironmentswhilepaving theway,developinginnovativeandbest-in-class pharmaceuticalassets,andkeepingstakeholders,investors, andshareholdersengaged.

Whatsignificantimpacthaveyoubroughttothelife scienceindustry?
Well,IthinkIhaveshownourteamandthelifescience industrythatpharmaceuticaldevelopmentofnew modalitiescanbebothswift,cost-efficient,andfun!
TellusaboutIlyaPharmaanditsfoundationpillar.
Themainobjectivesformygraduatestudieswereto developmoleculartollstosteerimmunecellbehaviour locally in vivo indifferentmodels.Whilstmanyofthe immuneactiveproteinsarewelldescribed,includingtheir functions,therearefewviableoptionstoutilisethese therapeutically.Forimmunecells,thespatialdistributionof localgradients in vivo isvitalforhowtoimpacttheir functionsintissue.
Toenabletargetingoftheseknownpathways,wedecided tomakealibraryoflacticacidbacteriathatcanbe geneticallyengineeredtoexpresshumanimmuneactive
proteins,forexamplechemokines,whichhaveahalf-lifeof secondsintissueandarethusnotsuitedfordevelopmentas biologicsorasgenetherapy
So,whatwemanufactureislacticacidbacteria;theseare activatedonsiteinthebodyandthenstarttoproducethe humantherapeuticprotein,oneofitsmostimportant USPs—almostforfree!
TheILP100,emilimogenesigulactibac,isourlead candidate,itisanon-humanstrainofa Limosciliobacillus reuteri (meaningitdoesnotstickto-orcolonizeinhumans) thatexpressesthechemokineCXCL12alsoknownasSDF1a.WearedevelopingILP100inatopicalformulation treatingsurgicalwoundsinobeseanddiabeticpatients,who havedelayedhealingandincreasedcomplications,andin anoralformulationtotreatcolitisincancerpatients,where 30-40%ofcancerpatientsoncheckpointinhibitortreatment needtodiscontinuethetreatmentduetoseverecolitis.
Wearestartingwiththesetwodrugcandidates,forward thereareawiderangeofpossibilitiesusingtheILPplatformandwemayexploremedicalindicationsinlung andwomen’shealthlimitingfibrosis.
HowdoesIlyaPharmapromoteworkforceflexibility, andwhatisyourroleinit?
AtIlyaPharma,theteamsworkfromsixcountries,andwe havemultiplevendorsglobally Wedohaveanoffice, whichismainlytooffertheteamaplacetomeetupator havequietfocusedtimewhenneeded.Ithinktheteam appreciatestheflexibilityandisgoodtoeachotherinthis
regard.Manyareparentsandadapttheirworkloadtofit withtheirfamily;thisworkswell,andwehavesolvedthis bymakingsmallinterchangeableexpertteamsinsteadof relyingononepersonhavingtheexpertiseonly.
Comingfromacademia,workinginglobalteams,being GenYandScandinavian-flexibilityissomethingIhave alwaystakenforgrantedandappreciated.Ihavebeen surroundedbypeopleandcollaboratorsthatworkatodd hoursfromremotelocationsbutalsoalwaysmakeitwork foradeadline,whateverthatmaybe.

Whatisyourtakeontechnology'simportance,andhow areyouleveragingit?
Itisimportanttoalwaysexplorenewoptionsand improvements,especiallywhenitcomestogeneratingand understandingdatafromthedifferentpartsofthe developmentprocess.Pharmaceuticaldevelopmentand healthcareare,however,quitetraditional,anditisnotthe first-placenewtechnologiesarebeingtestedandvalidated, asthebarmaybelowerforthefirstproofofconcept elsewhere.Wehavealsoexperiencedthatsmaller companieswithgreatnewtechnologies,forexamplein imaging,arehesitanttotakethestepofvalidation.So,we usenewtechnologiesforourclinicaltrialsinanticipationof leveragingthedatagoingforward,especiallyimagingand potentiallynewbiomarkers.
Whatwillbethenext significantchangeinthe lifescienceindustry,and howareyoupreparingfor it?

Havingthebest understandingofthe therapeuticsspace,Isee moreandmorenew modalitiesinearly developmentaswellasnew andinnovativetakeson immunotherapiesforawide rangeofunmetneeds beyondcancer.Ithinkthe regulators,withtheFDA havingadaptedthemostto meettheseprojects,are ready,butthatthe pharmaceuticalindustry, especiallybigpharma,may bewisetostayconnectedandbereadyfortheeverchanging,fasterpaceofproductdevelopmentthatmaynot fittraditionalsilosandindications—thereisstillavast unmetmedicalneedtobeaddressed.
Whatareyourgoalsintheupcomingfuture?
Iam,ofcourse,focusedondeliveringtheclinicaland commercialmilestonesforIlyaPharma’sassets.Having identifiedgapsinthemarketforcell-andgenetherapy productdevelopmentinfrastructureandservices,especially forlatestageclinicalandcommercialapplications,itwould begreattobeabletoleveragetheCMCknow-howwehave gatheredandmaybetapintoorbuildouttheinfrastructure forusandforothers,facilitatingthePoCinpatientsofdrug candidatesfornewmodalities.
Whatadvicewouldyouliketogivethenextgeneration ofaspiringbusinessleaders?
Thisismyfirstdownturnintheeconomyasabusiness leaderandCEO.Navigatingclinicaldevelopmentsduring thepandemicwaschallenginghoweverchanging macroeconomicconditionsduringlongdevelopment projectsinLifeSciencerequiresthatYoutohavemultiple doorsopenandbemoreagileandopentoexplore opportunitieswhereYouinitiallymaybedidnotexpectto findthem!




